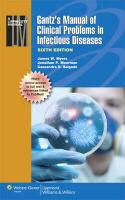

Description
Product details
| Authors | Jonathan P. Moorman, James Myers, James W. Myers, James W. Moorman Myers, MYERS JAMES W MOORMAN JONATHAN, Cassandra D. Salgado |
| Publisher | Lippincott |
| Languages | English |
| Product format | Paperback / Softback |
| Released | 31.10.2012 |
| EAN | 9781451116977 |
| ISBN | 978-1-4511-1697-7 |
| No. of pages | 656 |
| Series |
Lippincott Manual Lippincott Manual |
| Subject |
Natural sciences, medicine, IT, technology
> Medicine
> Clinical medicine
|
Customer reviews
No reviews have been written for this item yet. Write the first review and be helpful to other users when they decide on a purchase.
Write a review
Thumbs up or thumbs down? Write your own review.